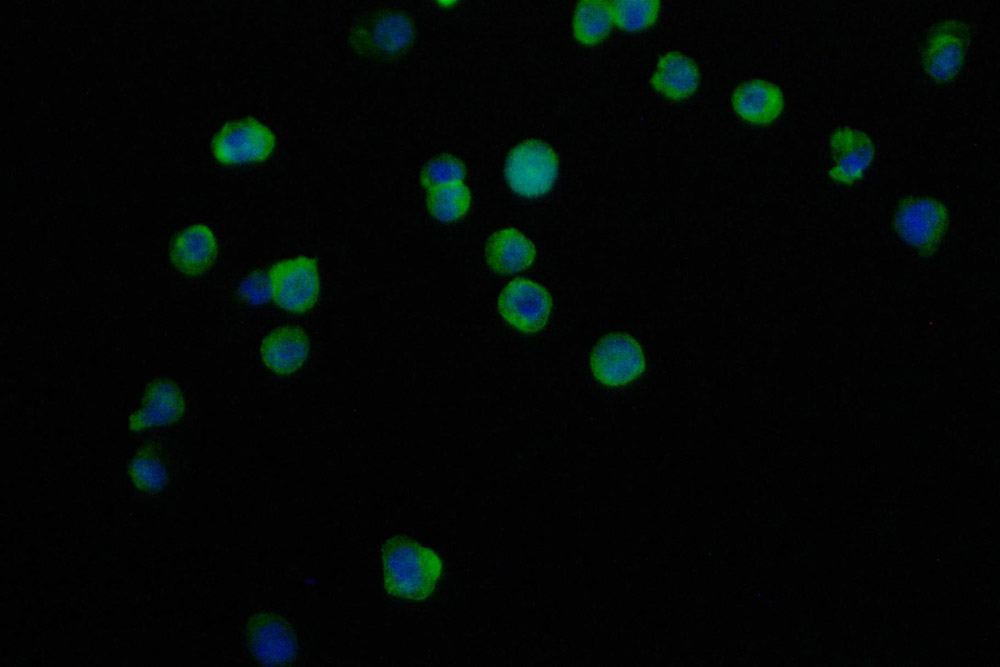
CSB-RA787996A0HU IF

特發性肺纖維化(IPF)是一種慢性、進行性、致死性的間質性肺炎,以肺組織不可逆性纖維化重塑為特征,最終導致呼吸衰竭。其核心病理機制包括肺泡上皮細胞反復損傷、異常修復,驅動成纖維細胞活化為肌成纖維細胞,導致細胞外基質過度沉積,形成肺瘢痕。臨床表現為活動性呼吸困難、干咳、疲勞,常伴肺功能進行性下降,約50%患者合并間質性肺病(ILD)。IPF主要影響50歲以上人群,中位生存期僅2-5年,預后差于多數癌癥,故被稱為"不是癌癥的癌癥"。?
特發性肺纖維化(IPF)的藥物研發聚焦于纖維化、炎癥及細胞修復等核心機制,主要關注以下靶點:
● 轉化生長因子-β(TGF-β)通路:現有藥物尼達尼布通過抑制TGF-β下游受體(VEGFR、PDGFR、FGFR)延緩肺功能下降。百時美施貴寶的BMS-986278(Admilparant)作為溶血磷脂酸受體1(LPAR1)拮抗劑,其II期研究顯示可降低FVC年下降率54%,目前III期試驗正在進行中。
● 磷酸二酯酶 4B(PDE4B):勃林格殷格翰的口服抑制劑nerandomilast在III期臨床試驗 FIBRONEER-IPF中顯著減緩FVC下降,且安全性可控,已在中國提交上市申請并被納入優先審評。
● 結締組織生長因子(CTGF):Pliant Therapeutics的Bexotegrast(PLN-74809)通過抑制CTGF與TGF-β結合,在IIa期試驗中顯示FVC下降幅度減少,目前進入IIb/III期臨床。
目前,特發性肺纖維化新藥研發正朝著多靶點與新型機制方向突破。英矽智能借助AI發現TNIK激酶抑制劑INS018_055,臨床前展現優于尼達尼布的抗纖維化效果,且與吡非尼酮聯用增效;北京生命科學研究所鎖定AREG蛋白為關鍵靶點,其抑制劑已進入一期臨床。細胞療法領域,上海交通大學的自體基底干細胞移植、吉美瑞生的REGEND001氣道基底層干細胞療法均在臨床試驗中取得肺功能改善等積極成果。此外,韓國研究證實依折麥布可抑制成纖維細胞分化,中國學者發現GOLM1-KLF4-NEAT1信號通路具備潛在價值,為IPF治療帶來新希望。
特發性肺纖維化在研藥物靶點
特發性肺纖維化藥物靶點相關產品推薦
● 靶點蛋白
CSB-MP5112MOW

Measured by its binding ability in a functional ELISA. Immobilized Rhesus macaque CTGF at 1 μg/ml can bind Anti-CTGF recombinant antibody (CSB-RA006147MA2HU). The EC50 is 0.6886-0.7825 ng/mL.
CSB-MP878942HU1

Measured by its binding ability in a functional ELISA. Immobilized PD-L1 at 2 μg/ml can bind Anti- PD-L1 mouse monoclonal antibody(CSB-MA878942A1m,antigen from E.coli), the EC50 of human PD-L1 protein is 1.252-1.653 ng/mL.
CSB-MP006254HU(F1)
-AC1.jpg)
Measured by its binding ability in a functional ELISA. Immobilized Human CXCR4 at 10 μg/ml can bind Anti-CXCR4 recombinant antibody (CSB-RA006254MA01HU), the EC50 is 101.7-253.6 ng/mL.
CSB-MP723415HU

Measured by its binding ability in a functional ELISA. Immobilized CD73 at 2 μg/ml can bind Anti- CD73 Rabbit Monoclonal Antibody(CSB-RA978310A0HU), the EC50 is 3.212-4.525 ng/ml.
| Target | Product Name | Source | Tag Info | Code |
|---|---|---|---|---|
| CCL2 | Recombinant Human C-C motif chemokine 2 (CCL2) | E.coli | N-terminal GST-tagged | CSB-EP004783HU |
| CCL2 | Recombinant Human C-C motif chemokine 2 (CCL2) | E.coli | N-terminal 10xHis-tagged and C-terminal Myc-tagged | CSB-EP004783HUb1 |
| CCL2 | Recombinant Mouse C-C motif chemokine 2 (Ccl2), partial | E.coli | N-terminal 6xHis-tagged | CSB-EP004783MO |
| CCN2 | Recombinant Human CCN family member 2 (CCN2) | E.coli | C-terminal 6xHis-tagged | CSB-EP006147HU |
| CCN2 | Recombinant Human CCN family member 2 (CCN2), partial | E.coli | N-terminal 6xHis-tagged | CSB-EP006147HU1 |
| Ccn2 | Recombinant Mouse CCN family member 2 (Ccn2), partial | E.coli | N-terminal 10xHis-SUMO-tagged | CSB-EP006147MO |
| Ccn2 | Recombinant Mouse CCN family member 2 (Ccn2), partial | E.coli | N-terminal GST-tagged | CSB-EP006147MOe0 |
| CCN2 | Recombinant Macaca mulatta CCN family member 2 (CCN2) (Active) | Mammalian cell | C-terminal 10xHis-tagged | CSB-MP5112MOW |
| Ccn4 | Recombinant Rat CCN family member 4 (Ccn4), Biotinylated | E.coli | N-terminal MBP-tagged and C-terminal 6xHis-Avi-tagged | CSB-EP857523RA-B |
| CCR7 | Recombinant Human C-C chemokine receptor type 7 (CCR7), partial | E.coli | N-terminal 10xHis-tagged and C-terminal Myc-tagged | CSB-EP004846HU1 |
| CCR7 | Recombinant Human C-C chemokine receptor type 7 (CCR7) | in vitro E.coli expression system | N-terminal 6xHis-tagged | CSB-CF004846HUa0 |
| CD274 | Recombinant Human Programmed cell death 1 ligand 1 (CD274), partial | E.coli | N-terminal 10xHis-tagged and C-terminal Myc-tagged | CSB-EP878942HU2 |
| CD274 | Recombinant Human Programmed cell death 1 ligand 1 (CD274), partial (Active) | Mammalian cell | C-terminal hFc1-tagged | CSB-MP878942HU1 |
| CD274 | Recombinant Dog CD274 molecule (CD274), partial | Mammalian cell | C-terminal 10xHis-tagged | CSB-MP5015DO1 |
| CD274 | Recombinant Human Programmed cell death 1 ligand 1 (CD274), partial ( (K136A)) | E.coli | N-terminal 6xHis-tagged | CSB-EP878942HU1(M) |
| CD274 | Recombinant Human Programmed cell death 1 ligand 1 (CD274) (K136A), partial | Yeast | C-terminal 6xHis-tagged | CSB-YP878942HU1(M)c7 |
| CD274 | Recombinant Human Programmed cell death 1 ligand 1 (CD274), partial | Mammalian cell | C-terminal 10xHis-tagged | CSB-MP878942HU1d7 |
| Cldn1 | Recombinant Rat Claudin-1 (Cldn1), partial | E.coli | N-terminal 10xHis-tagged and C-terminal Myc-tagged | CSB-EP005490RA1 |
| CLDN1 | Recombinant Human Claudin-1 (CLDN1) | in vitro E.coli expression system | N-terminal 10xHis-tagged | CSB-CF005490HU |
| CLDN1 | Recombinant Human Claudin-1 (CLDN1)-VLPs | Mammalian cell | C-terminal 10xHis-tagged (This tag can be tested only under denaturing conditions) | CSB-MP005490HU |
● 抗體
CSB-RA878942MA1HU

Tested Applications:
ELISA, IHC, FC
CSB-RA796695A0HU

Tested Applications:
ELISA, WB, IHC
CSB-RA787996A0HU
Tested Applications:
ELISA, WB, IF
CSB-RA259644A0HU

Tested Applications:
ELISA, WB, IHC
- 重組抗體
| Target | Product Name | Species Reactivity | Tested Applications | Code |
|---|---|---|---|---|
| CD274 | CD274 Recombinant Monoclonal Antibody | Human | ELISA, WB, IHC | CSB-RA977797A0HU |
| CD274 | CD274 Recombinant Monoclonal Antibody | Human | ELISA, IHC, FC | CSB-RA878942MA1HU |
| CD38 | CD38 Recombinant Monoclonal Antibody | Human | ELISA, WB, IHC | CSB-RA796695A0HU |
| CD40 | CD40 Recombinant Monoclonal Antibody | Human | ELISA, IF, FC | CSB-RA004936MA1HU |
| GCGR | GCGR Recombinant Monoclonal Antibody | Human | ELISA | CSB-RA009316A1HU |
| IL17A | IL17A Recombinant Monoclonal Antibody | Human | ELISA | CSB-RA624104MA1HU |
| IL23A | IL23A Recombinant Monoclonal Antibody | Human | ELISA, WB | CSB-RA251959A0HU |
| IL6 | IL6 Recombinant Monoclonal Antibody | Human | ELISA | CSB-RA011664MA1HU |
| ITGAL | ITGAL Recombinant Monoclonal Antibody | Human | ELISA, WB, IF | CSB-RA787996A0HU |
| MS4A1 | CD20 Recombinant Monoclonal Antibody | Human | ELISA | CSB-RA015007A0HU |
| MS4A1 | MS4A1 Recombinant Monoclonal Antibody | Human | ELISA | CSB-RA015007A1HU |
| MS4A1 | MS4A1 Recombinant Monoclonal Antibody | Human, Dog, Macaca fascicularis | ELISA | CSB-RA015007MA3HU |
| MS4A1 | MS4A1 Recombinant Monoclonal Antibody | Human | ELISA, IHC, IF | CSB-RA015007MA4HU |
| PCSK9 | PCSK9 Recombinant Monoclonal Antibody | Human | ELISA, WB, IHC | CSB-RA259644A0HU |
| SELPLG | SELPLG Recombinant Monoclonal Antibody | Human | ELISA, IHC | CSB-RA567010A0HU |
- 單克隆抗體
| Target | Product Name | Species Reactivity | Tested Applications | Code |
|---|---|---|---|---|
| CD2 | CD2 Monoclonal Antibody | Human,Mouse,Rat | ELISA, IHC | CSB-MA000227 |
| CD2 | CD2 Monoclonal Antibody,FITC Conjugated | Human | ELISA, IF, FC | CSB-MA785710 |
| CD38 | CD38 Monoclonal Antibody | Human | ELISA, IHC | CSB-MA785760 |
| IL1B | IL1B Monoclonal Antibody | Human | ELISA | CSB-MA065741A0m |
| IL1B | IL1B Monoclonal Antibody | Human | ELISA, WB, IHC, ICC | CSB-MA010884 |
| IL6 | IL6 Monoclonal Antibody | Human | ELISA, WB, IHC | CSB-MA067571A0m |
| ITGAL | ITGAL Monoclonal Antibody,FITC Conjugated | Human | ELISA, IF, FC | CSB-MA120024 |
| ITGAL | ITGAL Monoclonal Antibody,PE Conjugated | Human | ELISA, IF, FC | CSB-MA897229 |
| MS4A1 | MS4A1 Monoclonal Antibody | Human,Mouse,Rat | ELISA, IHC | CSB-MA000204 |
| MS4A1 | MS4A1 Monoclonal Antibody | Human | ELISA, IHC | CSB-MA996413 |
| TNF | TNF Monoclonal Antibody | Bovine | ELISA | CSB-MA084771A0m |
| TNF | TNF Monoclonal Antibody | Human,Mouse,Rat | ELISA, WB, IHC | CSB-MA080271 |
| TNF | TNF Monoclonal Antibody | Human,Mouse,Rat | ELISA, WB, IHC | CSB-MA080272 |
- 多克隆抗體
| Target | Product Name | Species Reactivity | Tested Applications | Code |
|---|---|---|---|---|
| CD2 | CD2 Antibody | Human | ELISA, IHC, IF | CSB-PA004894LA01HU |
| CD2 | CD2 Antibody | Human | ELISA, WB | CSB-PA005194 |
| CD2 | CD2 Antibody | Human | ELISA, WB | CSB-PA004894GA01HU |
| CD274 | CD274 Antibody | Human | ELISA, IHC | CSB-PA878942ESR1HU |
| CD274 | CD274 Antibody | Human, Mouse, Rat | ELISA, WB, IHC | CSB-PA004911GA01HU |
| CD28 | CD28 Antibody | Human | ELISA, WB | CSB-PA005199 |
| CD28 | Phospho-CD28 (Y218) Antibody | Human, Mouse | ELISA, WB | CSB-PA070302 |
| CD38 | CD38 Antibody | Human | ELISA, IHC | CSB-PA004929ESR1HU |
| CD38 | CD38 Antibody | Human | ELISA, WB | CSB-PA005628 |
| CD38 | CD38 Antibody | Human | ELISA, WB | CSB-PA134528 |
| CD38 | CD38 Antibody | Human | ELISA, WB, IHC | CSB-PA926996 |
| CD3D | CD3D Antibody | Human | ELISA, IHC | CSB-PA004930ESR1HU |
| CD3D | CD3D Antibody | Human | ELISA, WB | CSB-PA001452 |
| CD3D | CD3D Antibody | Human | ELISA, WB | CSB-PA005826 |
| CD3D | CD3D Antibody | Human, Mouse, Rat | ELISA, WB, IF | CSB-PA004930GA01HU |
| CD40 | CD40 Antibody | Human, Mouse | ELISA, WB, IF | CSB-PA004936LA01HU |
| CD40 | CD40 Antibody | Human, Mouse, Monkey | ELISA, WB, IHC | CSB-PA001455 |
| CD40 | Phospho-CD40 (T254) Antibody | Human, Mouse | ELISA, WB | CSB-PA080031 |
| CD40 | CD40 Antibody | Human | ELISA, WB | CSB-PA004936GA01HU |
| CD40 | CD40 Antibody | Human, Mouse | ELISA, IHC | CSB-PA215588 |
● ELISA試劑盒

Mouse Interleukin 13,IL-13 ELISA Kit
CSB-E04602m
| Target | Product Name | Sample Types | Detection Range | Code |
|---|---|---|---|---|
| CCL2 | Human high sensitivity C-C motif chemokine 2 (CCL2) ELISA kit | serum, plasma, tissue homogenates | 6.25 pg/mL-400 pg/mL | CSB-EQ004783HU |
| TGFB1 | Rat Transforming Growth Factor β1(TGF-β1) ELISA kit | serum, plasma, cell culture supernates, tissue homogenates | 6.25 pg/mL-400 pg/mL | CSB-E04727r |
| TGFB1 | Human Transforming Growth factor β1,TGF-β1 ELISA kit | serum, plasma, cell culture supernates | 0.78 ng/mL-50 ng/mL | CSB-E04725h |
| TGFB1 | Mouse Transforming Growth factor β1,TGF-β1 ELISA kit | serum, plasma, cell culture supernates | 0.78 ng/mL-50 ng/mL | CSB-E04726m |
| CCL2 | Mouse monocyte chemotactic protein 1/monocyte chemotactic and activating factor,MCP-1/MCAF ELISA kit | serum, plasma, tissue homogenates | 78 pg/mL-5000 pg/mL | CSB-E07430m |
| CCL2 | Rat monocyte chemotactic protein 1/monocyte chemotactic and activating factor,MCP-1/MCAF ELISA kit | serum, plasma, tissue homogenates | 31.25 pg/mL-2000 pg/mL | CSB-E07429r |
| IL13 | Mouse Interleukin 13,IL-13 ELISA Kit | serum, plasma, tissue homogenates | 78 pg/ml - 5000 pg/ml | CSB-E04602m |
| CCL2 | Human monocyte chemotactic protein 1/monocyte chemotactic and activating factor,MCP-1/MCAF ELISA kit | serum, plasma, urine, saliva, cerebrospinal fluid (CSF), ascitic fluid, cell culture supernates, tis | 6.25 pg/ml-400 pg/ml. | CSB-E04655h |
| CD274 | Human Programmed Death Ligand-1(PD-L1/CD274) ELISA Kit | serum, plasma, tissue homogenates, cell lysates | 15.6 pg/mL-1000 pg/mL | CSB-E13644h |
| IL13 | Rat Interleukin 13,IL-13 ELISA KIT | serum, plasma, cell culture supernates, tissue homogenates | 7.8 pg/mL-500 pg/mL | CSB-E07454r |
| TGFB1 | Chicken Transforming Growth factor β1,TGF-β1 ELISA kit | serum, plasma, tissue homogenates | 0.312 ng/mL-20 ng/mL | CSB-E09875Ch |
| IL13 | Human Interleukin 13,IL-13 ELISA KIT | serum, plasma, tissue homogenates | 0.39 ng/ml-25 ng/ml. | CSB-E04601h |
| CLDN1 | Human Claudin-1(CLDN1) ELISA kit | serum, plasma, tissue homogenates, cell lysates | 15.6 pg/mL-1000 pg/mL | CSB-EL005490HU |
| TGFB1 | Pig transforming growth factor β1(TGF-β1)ELISA Kit | serum, plasma | 0.78 ng/mL-50 ng/mL | CSB-E06843p |
| IL11 | Mouse Interleukin 11,IL-11 ELISA KIT | serum, plasma, tissue homogenates | 78 pg/ml - 5000 pg/ml | CSB-E04597m |
| CCL2 | Rabbit monocyte chemotactic protein 1/monocyte chemotactic and activating factor,MCP1/MCAF ELISA kit | serum, plasma, tissue homogenates | 23.5 pg/mL-1500 pg/mL | CSB-E06921Rb |
| ENO1 | Human Alpha-enolase (ENO1/ENO1L1/MBPB1/MPB1) ELISA kit | serum, tissue homogenates, plasma | 0.312 ng/mL-20 ng/mL | CSB-E17177h |
| CXCR4 | Rat CXC-chemokine receptor 4(CXCR4)ELISA Kit | serum, plasma, cell culture supernates, tissue homogenates | 0.156 ng/mL-10 ng/mL | CSB-E12703r |
| CXCR4 | Human CXC-chemokine receptor 4(CXCR4)ELISA Kit | serum, plasma, tissue homogenates | 15.6 pg/mL-1000 pg/mL | CSB-E12825h |
| CCL2 | Pig monocyte chemotactic protein 1,MCP1 ELISA Kit | serum, plasma | 31.25 pg/mL-2000 pg/mL | CSB-E13178p |















